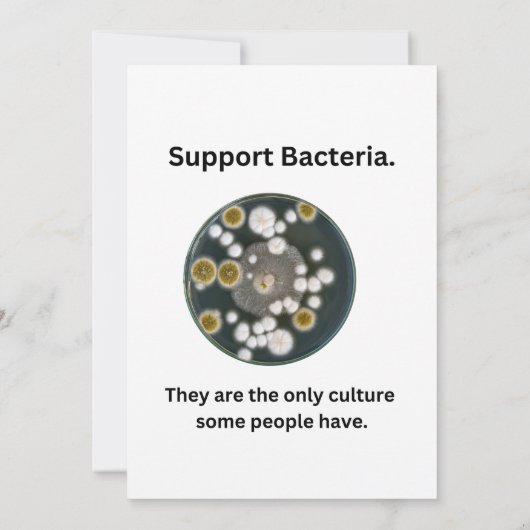
Steun Bacteria kaart (Achterkant)

Over Enkele kaartjes
Aangeboden door
Over dit ontwerp
Steun Bacteria kaart
Support Bacteria kaart is een leuke manier om mensen eraan te herinneren om voor hun bacteriecultuur te zorgen. Anders kan de schimmel hun bord besmetten. Het beste voor microbiologen.
Ontwerp van international designer
Klant beoordelingen
5.0 van 5 sterren beoordeling1 aantal beoordelingen
1 Reviews
Beoordelingen voor identieke producten
5 van 5 sterren beoordeling
Door Gerriejanne D.23 februari 2021 • Geverifieerde aankoop
Zazzler recensent programma
Mooie stevige kaart met unieke print. Prima. Maar print is wel fragiel ivm beschadigingen.
Tags
Andere Info
Product ID: 256017826266264198
Ontworpen op: 28-9-2023 9:16
Rating: G
Recent bekeken items